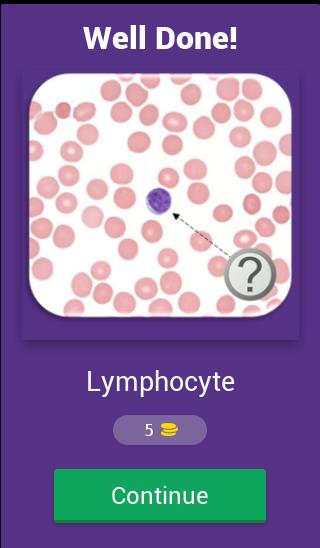
gallery

Hematology Quiz Questions 🔬 PC
DruApps
Download Hematology Quiz Questions 🔬 on PC With GameLoop Emulator
Hematology Quiz Questions 🔬 on PC
Hematology Quiz Questions 🔬, coming from the developer DruApps, is running on Android systerm in the past.
Now, You can play Hematology Quiz Questions 🔬 on PC with GameLoop smoothly.
Download it in the GameLoop library or search results. No more eyeing the battery or frustrating calls at the wrong time any more.
Just enjoy Hematology Quiz Questions 🔬 PC on the large screen for free!
Hematology Quiz Questions 🔬 Introduction
Hematology Quiz Questions free app.
You have several reasons to play it:
▪️ We have 40 levels +
▪️ Red series, white series and platelet series
▪️ Earn coins and buy tips.
▪️ Awesome design and gameplay.
▪️ FREE!
Hematology, also spelled haematology, is the science or study of blood, blood-forming organs and blood diseases. The medical aspect of hematology is concerned with the treatment of blood disorders and malignancies, including types of hemophilia, leukemia, lymphoma and sickle-cell anemia.
Four major areas of study within hematology include hemoglobinopathy, hematological malignancies, anemia and coagulopathy. Hemoglobinopathy is the study of abnormality in the globin chains of hemoglobin molecules. In addition to sickle cell anemia, thalassemia (also known as erythropoiesis) is part of hemoglobinopathy. The area of hematological malignancies is concerned with the diagnosis and treatment of cancers of the bone marrow, blood and lymph nodes. Myeloma is one type of hematological malignancy, along with leukemia and lymphoma. Other disorders treated by a hematologist include arterial thromboembolism, deep-vein thrombosis and neutropenia.
Tags: haematology, Hemato Quiz, Trivia, Evaluation, test, atlas, Exam Prepv
Information
Developer
DruApps
Latest Version
3.8.7z
Last Updated
2018-06-12
Category
Trivia
Available on
Google Play
Show More
How to play Hematology Quiz Questions 🔬 with GameLoop on PC
1. Download GameLoop from the official website, then run the exe file to install GameLoop
2. Open GameLoop and search for “Hematology Quiz Questions 🔬” , find Hematology Quiz Questions 🔬 in the search results and click “Install”
3. Enjoy playing Hematology Quiz Questions 🔬 on GameLoop
Minimum requirements
OS
Windows 8.1 64-bit or Windows 10 64-bit
GPU
GTX 1050
CPU
i3-8300
Memory
8GB RAM
Storage
1GB available space
Recommended requirements
OS
Windows 8.1 64-bit or Windows 10 64-bit
GPU
GTX 1050
CPU
i3-9320
Memory
16GB RAM
Storage
1GB available space